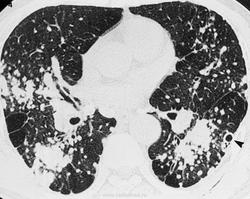

Пневмокониозы (греч. pneumōn легкое + konia пыль + -ōsis)- хронические заболевания легких, вызываемые длительным вдыханием пыли и характеризующиеся развитием фиброза легочной ткани. Практически всегда являются профессиональными заболеваниями.
В зависимости от вида воздействующей пыли выделено 6 групп пневмокониозов. К первой группе относится силикоз, развивающийся вследствие вдыхания пыли, содержащей диоксид кремния SiО2. Во вторую группу входят силикатозы (асбестоз, талькоз, каолиноз, нефелиноз, цементный, слюдяной пневмокониоз и др.), возникающие при вдыхании пыли силикатов, которые содержат диоксид кремния в связанном состоянии. Третья группа объединяет металлокониозы - П., обусловленные воздействием пыли металлов, например алюминия, бария, бериллия и его малорастворимых соединений, железа, марганца, олова, сурьмы, церия (алюминоз, баритоз, бериллиоз, сидероз, манганокониоз, станиоз и др.). Четвертая группа включает карбокониозы (антракоз, графитоз, сажевый пневмокониоз и др.), развивающиеся при вдыхании углеродсодержащих пылей. К пятой группе относятся П., вызываемые воздействием смешанных пылей (антракосиликоз, сидеросиликоз, силикосиликатоз, пневмокониоз электросварщиков и газорезчиков, пневмокониоз шлифовальщиков и др.). В шестую группу входят П., возникающие вследствие вдыхания органических пылей. содержащих частицы растительного или животного происхождения, а также микроорганизмы, обычно находящиеся на них, и продукты их жизнедеятельности. Эти заболевания отнесены к П. условно, т.к. не при всех из них наблюдается диссеминированный легочный процесс с развитием диффузного фиброза. Таким профессиональным заболеванием является биссиноз, характеризующийся развитием своеобразного бронхоспастического синдрома вследствие длительного вдыхания растительных волокнистых пылей хлопка, льна, конопли и др. При других заболеваниях, возникающих в результате воздействия органических пылей, возможны диффузные изменения в легочной ткани воспалительного или аллергического генеза с умеренной фиброзной реакцией. К ним относятся П., обусловленные пылью муки и зерна, пылью сахарного тростника (багассоз), пылью пластмасс. К этой группе заболеваний принадлежат также «легкое фермера», «легкое птицевода» и другие экзогенные аллергические альвеолиты, вызванные сенсибилизацией к органической пыли и грибкам.
Силикоз - наиболее распространенная и тяжело протекающая форма П. Особенно неблагоприятное течение отмечается при воздействии пыли с большим содержанием свободного диоксида кремния (у пескоструйщиков, обрубщиков, бурильщиков, проходчиков, размольщиков кварца и др.). В этих условиях силикоз может развиться при непродолжительном рабочем стаже (менее 10 лет), более выражена склонность к прогрессированию пневмофиброза и после прекращения контакта с пылью, чаще наблюдаются осложнения и развивается туберкулез. Рентгенологически в большинстве случаев выявляются узелковая и узловая формы процесса. При воздействии пыли с малым содержанием свободного диоксида кремния (менее 10%) чаще встречаются интерстициальная и мелкоузелковая формы силикоза, которые прогрессируют реже и медленнее. Силикоз отличается неблагоприятным течением у лиц, начавших работать в очень молодом и среднем (после 40 лет) возрасте.
Кун-Ил Ким, Чанг Вон Ким, Мин Ки Ли, Ген Су Ли, Чунг-Ки Парк, Сок Джин Чой, Чен Gi Kim.
"Кавитация" в результате ишемического некроза.
Антракоз. К карбокониозам в настоящее время относят пневмокониозы, вызванные вдыханием углеродсодержащей пыли. Наиболее распространенным видом пневмокониоза этой группы является антракоз, развитие которого обусловлено воздействием пыли каменного угля (антрацит, бурый уголь) или мягкого коксующегося угля.
Пылевую обстановку на современной шахте определяет механизированный выемочный участок, где основными источниками пылеобразования и пылевыделения являются такие технологические процессы, как разрушение угля и породы, погрузка, зачистка угля, передвижка секций крепи и забойного конвейера, транспортировка угля и породы от забоя до поверхности. Пыль угольных шахт смешанная, в ней практически всегда имеется примесь пород, содержащих свободную двуокись кремния, часто в качестве сопутствующей породы присутствуют песчаники и глинистые сланцы, содержащие от 4 до 70% свободной двуокиси кремния. Следовательно, пневмокониоз шахтеров-угольщиков обусловлен воздействием угольной и породной кварцсодержащей пыли и по своей этиологической природе является антракосиликозом. На развитие патологического процесса в легких оказывают также влияние присутствующие в забоях раздражающие газы (при проведении взрывных работ, при использовании дизельной техники) и неблагоприятные микроклиматические условия (сквозняки, обводненность). Антракоз — это пневмокониоз, возникающий при воздействии на легочную ткань угольной пыли.

Продолжение.
При рентгенологическом исследовании различают три формы П.: интерстициальную, узелковую и узловую (или конгломеративную), в развитии которых наблюдается определенная стадийность. Узелковые формы П. встречаются чаще всего при силикозе, антракозе и антракосиликозе, при некоторых металлокониозах (сидерозе, баритозе, манганокониозе, бериллиозе, сидеросиликозе). При П., вызываемых вдыханием пыли, не содержащей свободной двуокиси кремния, преобладают интерстициальные формы.
Для I стадии интерстициального П. характерна деформация легочного рисунка в виде диффузной сетчатости, занимающей нижние и средние пояса легочных полей. Тени корней умеренно расширены, их хвостовые отделы грубо тяжисты. В средних и нижних поясах местами выявляются парные полоски утолщенных стенок бронхов и кольцевидные тени - стенки бронхов в поперечном сечении. Часто на этом фоне видны единичные тени мелких узелков диаметром 1-2 мм. Прозрачность легочных полей слегка снижается за счет периваскулярных и перибронхиальных разрастаний соединительной ткани. Междолевые листки плевры утолщены и выявляются на рентгенограммах, выполненных в боковой проекции, в виде тонких линейных теней, обозначающих границы долей. Базальные отделы легких умеренно эмфизематозны, что проявляется повышением их прозрачности.
Во II стадии интерстициального П. наблюдается нарастание явлений фиброза. Деформация легочного рисунка по сетчатому типу видна на всем протяжении легочных полей, включая верхние пояса. Появляется множество мелких ;атенений неправильной формы - перекресты теней соединительно-тканных тяжей, утолщенные стенки бронхов и сосудов. Количество узелковых теней и их размеры несколько увеличиваются. Корни легких расширены, не структурны, уплотнены. Эмфизематозность нижних отделов легких нарастает. Экскурсия диафрагмы ограничена. Выявляются признаки увеличения правых отделов сердца.
В III стадии П. нарастают фиброзные изменения. Появляются неправильной формы затенения, обусловленные циррозом отдельных участков легких. Они чередуются с участками просветлений, отражающих наличие эмфизематозных булл. Корни продолжают расширяться. На их фоне на томограммах видны увеличенные лимфатические узлы: по краям отдельных узлов - участки обызвествления. Можно нередко выявить также увеличение паратрахеальных, трахеобронхиальных и бифуркационных лимфатических узлов. Диафрагма уплощена, углообразно деформирована, экскурсия ее незначительна.
При узелковом П. даже в начальных стадиях болезни изменения в легких более специфичны и их связь с профвредностью устанавливается более уверенно. В I стадии на фоне усиленного легочного рисунка обнаруживается множество узелковых образований диаметром 1-3 мм, большая часть которых концентрируется в прикорневых отделах легких. Форма узелков округлая, очертания четкие. Тени корней легких умеренно расширены, тяжисты.
Во II стадии узелкового П. на фоне ячеистого рисунка выявляется обычно большое количество узелковых образований, покрывающих все легочное поле, но более часто расположенных в средних и нижних поясах. Диаметр узелков может достигать 5 и даже 10 мм. В участках наиболее густой концентрации узелков легочный рисунок перекрыт их тенями; видны лишь отдельные обрывки линейных теней. В связи с этим и корни легких выглядят как бы обрубленными. В базальных отделах легких отмечается буллезная эмфизема. Экскурсия диафрагмы ограничена. Имеются плевродиафрагмальные и плевроперикардиальные спайки.
В III стадии П. узелки сливаются между собой, образуя крупные узлы или конгломераты. Между узлами можно выявить кавернозные полости, участки цирроза. В базальных отделах легких - буллезная эмфизема. Лимфатические узлы корней легких и средостения заметно увеличены, в их толще имеются включения солей кальция. В части случаев обызвествление лимфатических узлов носит краевой скорлупообразный характер. Диафрагма деформирована, фиксирована. Реберно-диафрагмальные синусы облитерированы. Сердце легочное.
Атипичные формы П., в частности односторонние поражения, встречаются редко, лишь при не очень далеко зашедшем процессе, обычно справа. При некоторых металлокониозах (сидерозе, станиозе, баритозе и др.) узелковые тени настолько интенсивны, что этот признак приобретает дифференциально-диагностическое значение. При интерстициальных П., наблюдаемых у лиц, работающих с органической пылью, а также с пылью, не содержащей свободной двуокиси кремния, отнесение диффузного пневмосклероза к профессиональному заболеванию возможно лишь после тщательного изучения анамнеза.
Острый силикоз.
Острый силикоз, также известный как silicoproteinosis - это редкое заболевание, связанное со значительным вдыханием свободного кремнезема в закрытых помещениях, в которых минимальна или отсутствует защита от от взыхания частиц кремния.
Для развития такого состояния часто достаточно 6-8 месяцев. Это заболевание часто быстро прогрессирует, смерть вызвана дыхательной недостаточностью.
Силикоз
Профессиональные заболевания лёгких
http://radiographics.rsna.org/content/21/6/1371.full
Силикоз
Случаи и цифры
Силикоз
Силикоз
Наблюдение Катенёва В.Л.
Силикоз
Силикоз.
Наблюдение Катенёва В.Л.
Силикоз (силико-туберкулёз)
Силикоз.